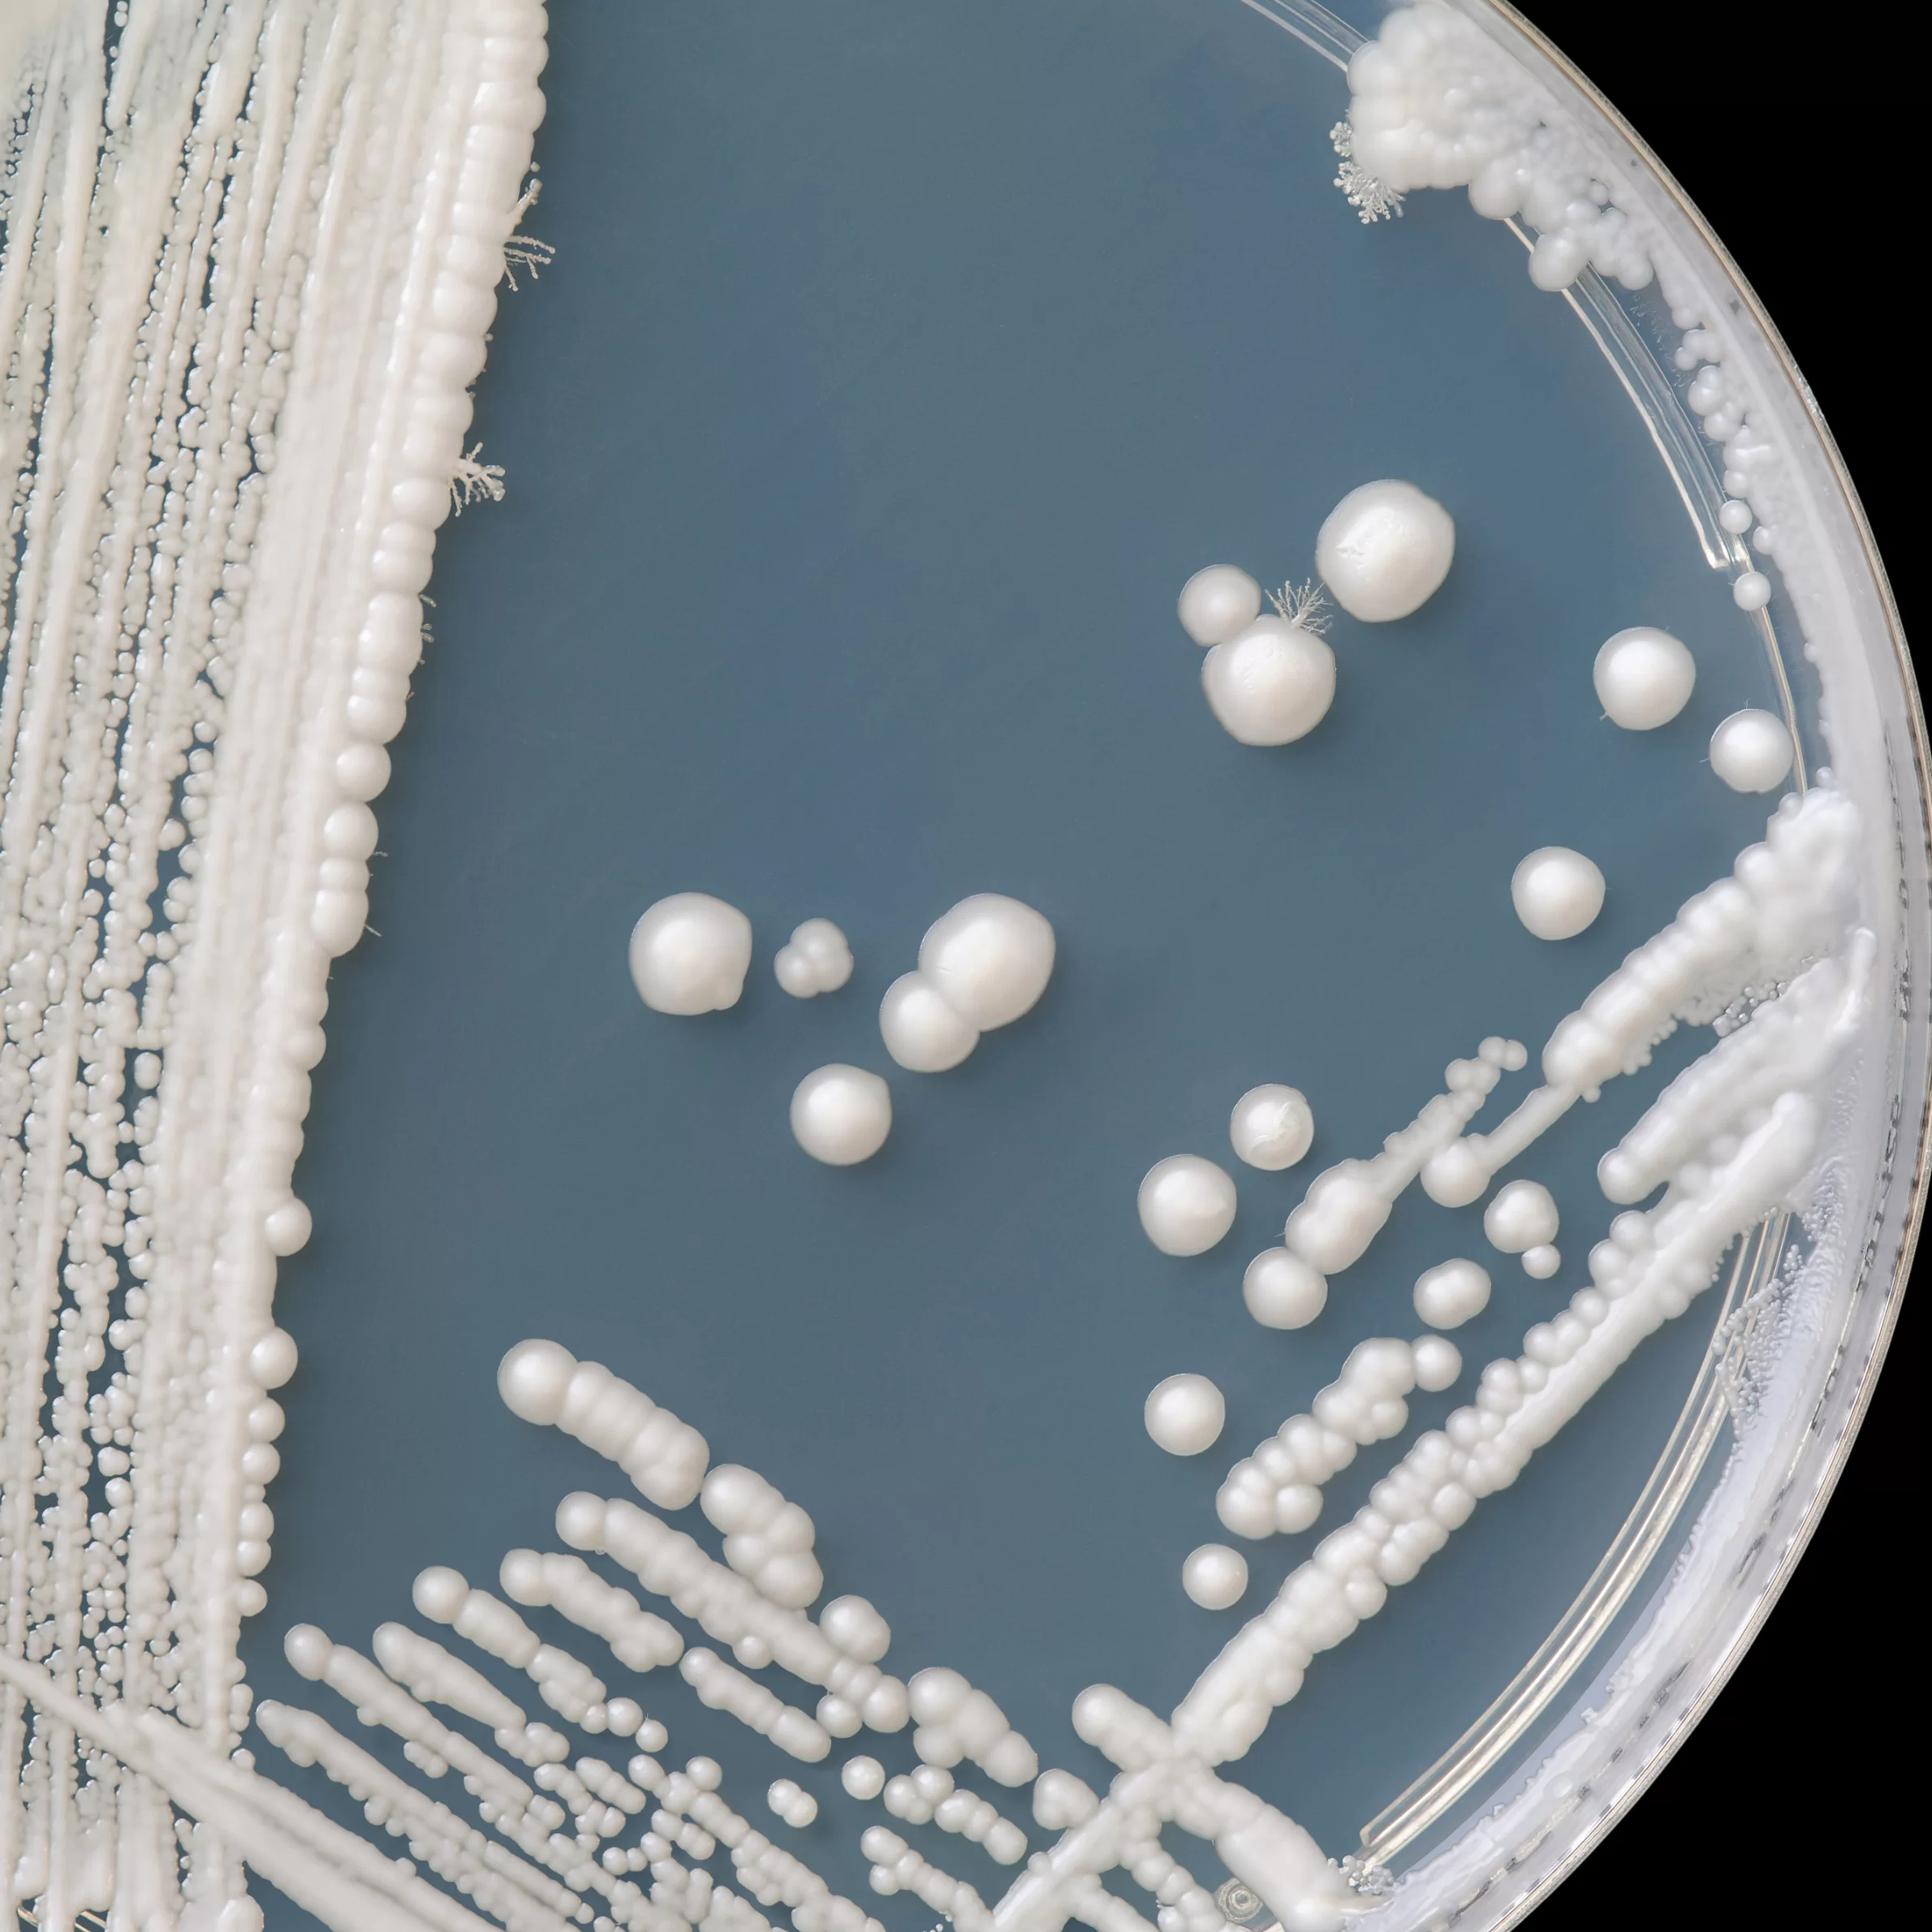

Blog Yazısı
Candida Mantarında Beslenme: Bilimsel Verilere Dayalı Rehber
📖 İçindekiler
Candida mantarı, bağışıklık sistemi zayıfladığında veya bağırsak mikrobiyotasının dengesi bozulduğunda aşırı çoğalabilen bir maya türüdür. Candida enfeksiyonları genellikle bağırsaklarda, ağızda, ciltte ve vajinal bölgede görülür. Bu durum "Candida aşırı büyümesi" olarak bilinir ve kronik yorgunluk, şişkinlik, sindirim sorunları, cilt döküntüleri ve bağışıklık sisteminin zayıflaması gibi semptomlara yol açabilir. Beslenme düzeni, Candida'nın kontrol altına alınmasında kritik bir rol oynar. Bu yazıda Candida mantarıyla mücadelede beslenmenin önemini, bilimsel araştırmalarla destekleyerek ele alacağız.
Candida Mantarı İçin Beslenme Prensipleri
Candida aşırı büyümesini önlemek veya mevcut semptomları hafifletmek için belirli besinleri sınırlandırmak ve bağırsak sağlığını destekleyen bir beslenme düzeni benimsemek gerekir. İşte bilimsel olarak desteklenen Candida diyetine uygun besinler ve kaçınılması gerekenler:
Kaçınılması Gereken Besinler
Candida mantarının büyümesini teşvik eden bazı besinler şunlardır:- Rafine Şeker ve Tatlandırıcılar: Candida mantarı, glikozu enerji kaynağı olarak kullanır. Şeker tüketimi arttıkça Candida da çoğalır. (Kaynak: "Diet and Nutrition in Fungal Diseases", Frontiers in Microbiology, 2021)
- Beyaz Un ve İşlenmiş Karbonhidratlar: Rafine tahıllar hızla şekere dönüşerek Candida'nın büyümesine katkıda bulunabilir.
- Alkol ve Fermente İçecekler: Alkol, bağırsak florasını bozarak Candida'nın çoğalmasına neden olabilir. (Kaynak: "Effect of Alcohol on Gut Microbiota and Its Influence on Candida Overgrowth", Journal of Fungi, 2020)
- Süt ve Yüksek Laktoz İçeren Süt Ürünleri: Laktoz, bağırsaklarda şekere dönüşerek Candida'nın beslenmesine katkı sağlar.
- Maya İçeren Gıdalar: Ekmek, mantar, fermente ürünler gibi mayalı gıdalar Candida büyümesini destekleyebilir.
Candida'yı Baskılayan Besinler
Candida ile mücadelede bağışıklık sistemini destekleyen ve bağırsak mikrobiyotasını dengeleyen besinler tüketilmelidir:- Lif Zengini Gıdalar: Tam tahıllar, sebzeler ve keten tohumu gibi lif kaynakları, sindirim sistemini destekleyerek Candida'nın çoğalmasını engelleyebilir.
- Probiyotik İçeren Gıdalar: Kefir, yoğurt, lahana turşusu gibi fermente gıdalar bağırsak florasını düzenleyerek Candida'nın aşırı büyümesini kontrol altına alabilir. (Kaynak: "Probiotics and Their Role in Candida Infections", Microorganisms, 2022)
- Hindistan Cevizi Yağı: Laurik asit ve kaprilik asit içeriği sayesinde antifungal etki gösterir.
- Sarımsak ve Soğan: Antimikrobiyal özellikleriyle Candida'nın çoğalmasını engelleyebilir. (Kaynak: "Antifungal Properties of Garlic", Journal of Medical Mycology, 2021)
- Zencefil ve Zerdeçal: Enflamasyonu azaltarak bağırsak sağlığını destekler.
Bağırsak Sağlığını Destekleyici Yaşam Tarzı Önerileri
Beslenmenin yanı sıra Candida mantarının aşırı büyümesini önlemek için yaşam tarzı değişiklikleri de gereklidir:- Düzenli Egzersiz: Bağışıklık sistemini destekleyerek enfeksiyon riskini azaltabilir.
- Stres Yönetimi: Stres, bağırsak mikrobiyotasını olumsuz etkileyerek Candida'nın çoğalmasına yol açabilir.
- Yeterli Su Tüketimi: Toksinlerin vücuttan atılmasını kolaylaştırır.
Sonuç
Candida mantarı aşırı büyümesi, doğru beslenme ve yaşam tarzı değişiklikleri ile kontrol altına alınabilir. Rafine şeker ve işlenmiş gıdalardan kaçınılmalı, probiyotikler, sağlıklı yağlar ve antifungal gıdalar beslenmeye dahil edilmelidir. Bilimsel araştırmalar, bu stratejilerin Candida kontrolünde etkili olduğunu göstermektedir. Eğer Candida aşırı büyümesi belirtileri yaşıyorsanız, bir sağlık profesyoneline danışarak beslenme düzeninizi şekillendirmek en doğru yaklaşım olacaktır.
Candida, bağışıklık sistemi zayıfladığında veya bağırsak mikrobiyotasının dengesi bozulduğunda aşırı çoğalabilen bir maya türüdür. Genellikle bağırsaklarda, ağızda, ciltte ve vajinal bölgede enfeksiyonlara yol açabilir.
Candida aşırı büyümesi, kronik yorgunluk, şişkinlik, sindirim sorunları, cilt döküntüleri ve bağışıklık sisteminin zayıflaması gibi semptomlarla kendini gösterebilir.
Rafine şekerler, beyaz un ve işlenmiş karbonhidratlar, alkol, yüksek laktoz içeren süt ürünleri ve maya içeren gıdalar Candida'nın büyümesini teşvik edebilir. Bu nedenle bu besinlerden kaçınılması önerilir.
Candida ile mücadelede lif zengini gıdalar (tam tahıllar, sebzeler), probiyotik içeren gıdalar (kefir, yoğurt), hindistan cevizi yağı, sarımsak, soğan, zencefil ve zerdeçal gibi besinler tüketilmelidir. Bu gıdalar bağışıklık sistemini destekler ve mikrobiyotu dengeleyerek Candida'nın aşırı büyümesini engeller.
Düzenli egzersiz, stres yönetimi ve yeterli su tüketimi Candida'nın aşırı büyümesini önlemek için etkili yaşam tarzı değişiklikleridir. Bu öneriler, bağışıklık sistemini güçlendirir ve bağırsak sağlığını destekler.
Reklam
Reklam
İlginizi Çekebilir

Miraç Kandili Nedir? 2026 Miraç Kandili Ne Zaman, Anlamı ve İbadetleri

Daha Fazla Su Tüketmemiz İçin 5 Neden

Sütün Bozulduğu Nasıl Anlaşılır? Bozuk Süt Belirtileri ve Saklama Yöntemleri

Vazopressin (ADH) Nedir? Görevleri, Eksikliği ve Sık Sık İdrara Çıkma İle İlişkisi

Kolajen Kullanmak Şart mı? Faydaları, Eksileri ve Doğal Alternatifleri

Diyette Dondurma Yenir mi? Sağlıklı Tatlı Seçimi
Yorum Yap & Değerlendir
Bu içeriğe yorum bırakmak veya değerlendirmek için giriş yapmalısınız.
Giriş Yap